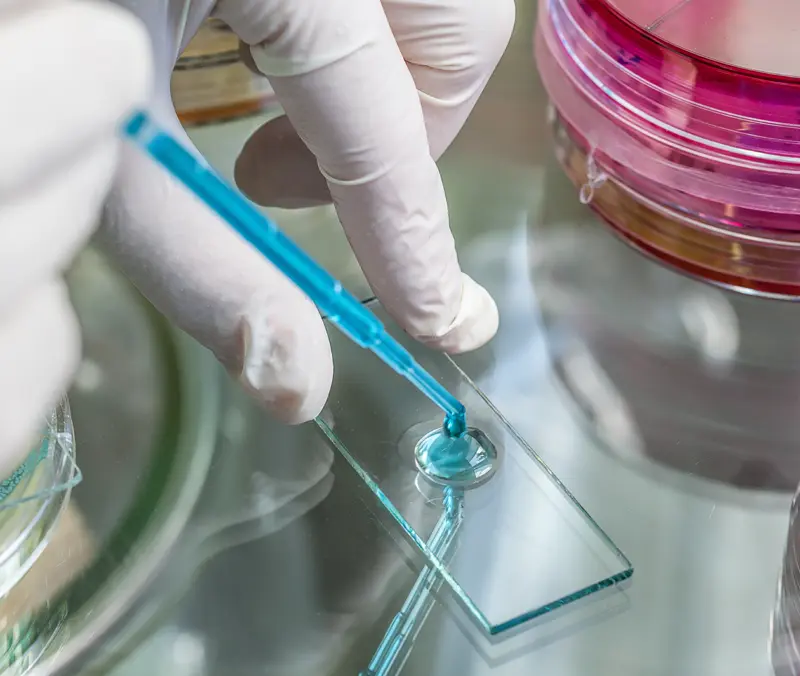
Legionella water testing in the laboratory

Water Testing:
Legionella
Our UKAS accreditation covers both 1L filtration and 200ml centrifugation methods so whether you are testing to comply with the guidance document HSG274 and other publications such as HSG282 for spa pools and the Healthcare Memorandums HTM 04-01 and HTM 01-05. The analysis we perform will be UKAS accredited. Both methods have a detection limit of 20 cfu/L
Legionella Analysis – what do the results mean?
We produce reports identifying both the total number of Legionella bacteria in either 200ml or a litre of water with details of which Sero group it belongs to. Occasionally you may find a sample contains more than one Sero type.
If no legionella colonies are isolated the result will be reported as not detected.
If your sample is positive for Legionella and the count is over 100 cfu/litre, you should refer to your risk assessment for escalation procedure and remediation.